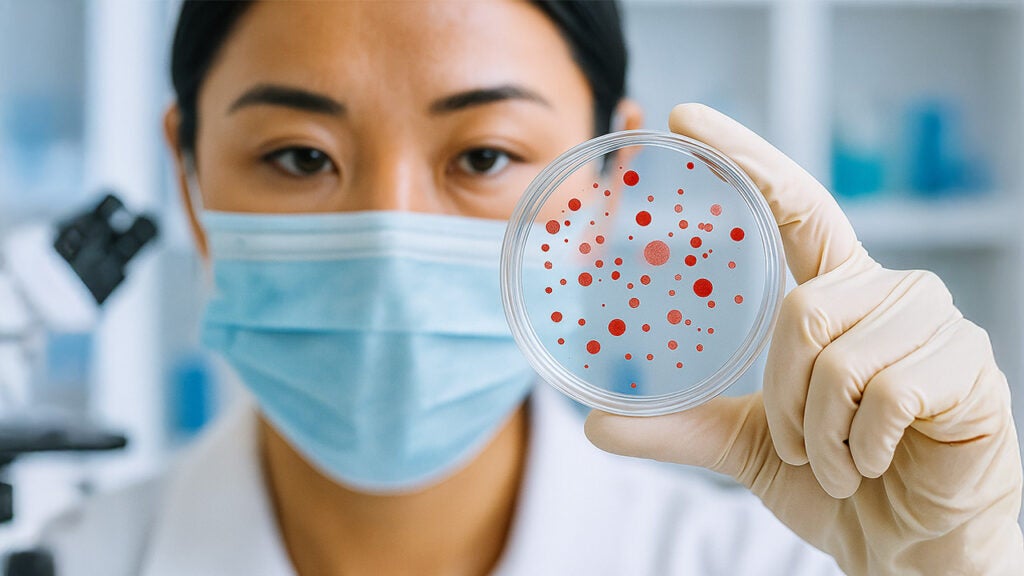

Our global health programmes bring together country-specific collaborations, disease-focused initiatives, and cross-cutting methodological expertise to address some of the most pressing health challenges in Asia. From long-standing partnerships in Cambodia and Lao PDR to region-wide networks tackling antimicrobial resistance and infectious disease outbreaks, our work spans maternal and child health, nutrition, mental health, and emerging threats like climate change and biological catastrophes. Through clinical trials, policy-relevant research, and capacity-building, these programmes reflect our School’s vision of impactful, locally informed global health practice grounded in lasting regional partnerships.
Asia Centre for Health Security (ACHS)
The Asia Centre for Health Security (ACHS) is an academic think tank that is dedicated to strengthening Asia’s readiness for current and emerging biological threats.

Programme Summary
By engaging in collaborative research, education initiatives, and strategic partnerships, ACHS envisions a united and resilient Asia safeguarded against health security threats for the well-being of future generations. ACHS is based at the SSHSPH, NUS, and operates in close partnership with the S. Rajaratnam School of International Studies (RSIS), Nanyang Technological University, and the National Centre for Infectious Diseases.
ADVANcing Clinical Evidence in Infectious Diseases (ADVANCE-ID)
The ADVANcing Clinical Evidence in Infectious Diseases (ADVANCE-ID) Network is a global network for infectious disease clinical studies.
Programme Summary
Our aim is to conduct rapid, cost-effective randomised controlled trials to deliver relevant and high-quality evidence to guide clinical practice. We hope to achieve this vision through equity (shared ownership), sustainability (building long-term capacity and trust) and engagement of key stakeholders (including clinicians, scientists, governments, and industry).
Mission:
To conduct high-quality clinical trials that have a global impact on the management of infections.
Vision:
To be the “go-to” for evaluation of new antimicrobials, diagnostics or prevention strategies relevant to antimicrobial resistance (AMR) and other infectious diseases.
Cambodia Programme
The Cambodia Programme, launched in 2014 by the Saw Swee Hock School of Public Health, is a long-term collaboration with multiple public health partners in Cambodia, including the Ministry of Health, to improve public health and strengthen health systems.

Programme Summary
Over the years, it has addressed priorities such as infectious diseases, antimicrobial resistance, maternal and child health, and non-communicable diseases, while building local research and implementation capacity. Moving forward, the programme will continue working with government ministries and regional partners to advance health policy, expand healthcare access, and promote sustainable, evidence-based solutions for communities in Cambodia and across Southeast Asia.
Centre for Health Intervention and Policy Evaluation Research (HIPER)
The Centre for Health Intervention and Policy Evaluation Research (HIPER) is dedicated to advancing evidence-informed health policy through rigorous research and strategic partnerships.

Programme Summary
Established in 2019, HIPER’s mission is to be the leading academic centre conducting high quality health technology assessment (HTA) and programme evaluation that contribute to policymaking locally and regionally. Its multidisciplinary team supports decision-makers in assessing the value, effectiveness, and impact of health interventions and service delivery models across areas such as mental health, chronic kidney disease, antimicrobial resistance, and precision medicine.
Beyond research HIPER actively builds regional capacity through technical training, short courses, and institutional support in HTA, real-world data analysis, and health economics.
The centre works closely with academics, ministries of health, healthcare providers, public health institutions and international collaborators—including the World Health Organization and the REALISE working group—to shape policies that promote equity, efficiency, and sustainability in health systems across Asia. Guided by the ethos “Evidence. Empower. Decisions.”, HIPER plays a pivotal role in strengthening healthcare decisions through robust evidence and applied insights
SSHSPH–Lao PDR Programme
Through collaborative research, capacity building, and evidence-informed policymaking, the NUS SSHSPH–Lao PDR Programme envisions a stronger public health system in Lao PDR that advances the well-being of its people.

Programme Summary
The programme is jointly led by the NUS SSHSPH and the Lao Tropical and Public Health Institute (Lao TPHI), and focuses on enhancing educational initiatives, co-supervising Master’s students, and facilitating research that informs public health policies. Working in close partnership, the programme undertakes joint research and intervention projects aligned with the national health research agenda, strengthens teaching and training collaborations, promotes staff and student exchanges, and explores funding opportunities to support shared research priorities.
To support these activities, the programme offers Fellowships for research, training, and pilot initiatives.
Southeast Asia Regional Collaborative for Health (SEARCH)
The Southeast Asia Regional Collaborative for Health (SEARCH) is a regional learning network made up of partners from ASEAN countries, Timor‑Leste, India, China, and international collaborators, all working toward strengthening health systems. It aims to advance Universal Health Coverage (UHC) in the region by raising leadership, research, policy, and practice capacity for strategic health purchasing and primary healthcare.

Programme Summary
SEARCH engages in evidence synthesis, capacity‑building, targeted training workshops, and policy engagement to build regional competencies for health systems strengthening. Central to its approach are two guiding tools: primary healthcare, which emphasises disease prevention, integrated care, and community empowerment to bring health closer to communities; and strategic health purchasing, which involves allocating health funds based on evidence to improve fiscal efficiency, cost‑effectiveness, service quality, and accessibility. SEARCH works closely with national governments, health ministries, insurance agencies, public health professionals, and the private sector to implement these initiatives, thereby driving progress toward Universal Health Coverage across the region.
Modelling Infectious Diseases in South East Asia (MIDSEA)
The Modelling Infectious Diseases in South East Asia (MIDSEA) Network is a consortium of researchers around the region working on all aspects of infectious disease modelling.

Programme Summary
The network provides a platform to share ideas, meet collaborators, and organise events to advance the use of modelling in informing policy in South East Asia. The Centre for Epidemic Research and Modelling at NUS School of Public Health is currently the coordinating centre for the network and our members are active in many of the network’s activities, which include monthly webinars, the early career researcher group, and in-person events such as workshops and the annual MIDSEA Summer School.